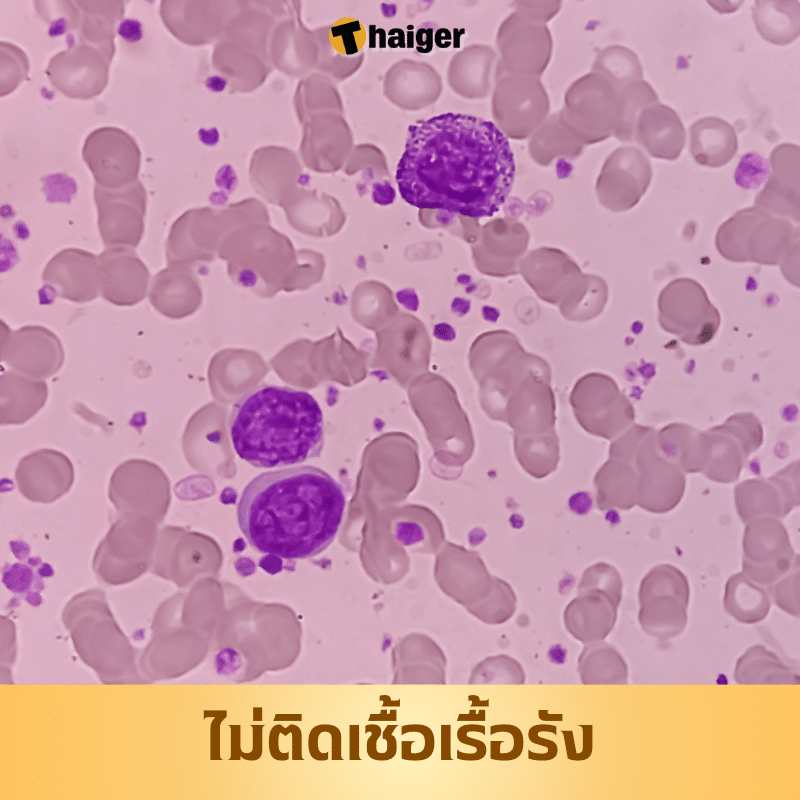
คนมีภูมิคุ้มกันมะเร็งไม่ติดเชื้อเรื้อรัง

แม้โรคมะเร็งจะสัมพันธ์กับพันธุกรรม แต่ก็ใช่ว่าจะเกิดจากสาเหตุนี้เพียงอย่างเดียว ยังมีปัจจัยอื่นๆ ทั้งอายุ พฤติกรรมการใช้ชีวิต สิ่งแวดล้อม อาชีพ ล้วนมีส่วนสำคัญ ที่ทำให้เราเกิดความเสื่อมก่อนเวลา และพัฒนาเป็นมะเร็งร้ายได้
แพทย์หลายคนออกมาแนะนำว่า หากคุณต้องการมะเร็งป้องกันได้ แนะนำให้ทำ 5 ข้อนี้ในชีวิตประจำวัน
1. ขยันออกกำลังกาย
การออกกำลังกายช่วยเสริมสร้างภูมิคุ้มกันให้ร่างกายแข็งแรง ทำให้ระบบภูมิคุ้มกันตรวจจับและกำจัดเซลล์ผิดปกติได้ทันท่วงที คนที่มีน้ำหนักเกิน มีแนวโน้มเป็นโรคมะเร็งได้ง่ายกว่า เนื่องจากมักเกิดการอักเสบเรื้อรัง ซึ่งเป็นปัจจัยเสี่ยงต่อการเกิดโรคมะเร็ง การออกกำลังกายเป็นประจำจึงช่วยควบคุมน้ำหนักให้อยู่ในเกณฑ์ปกติ ลดโอกาสการเกิดโรคอ้วน และลดความเสี่ยงของโรคมะเร็งได้

2. อยู่ห่างเหล้า บุหรี่
พฤติกรรมเสี่ยงอย่างการดื่มสุราและสูบบุหรี่ ส่งผลเสียต่อสุขภาพอย่างมาก การสูบบุหรี่ทำให้ร่างกายได้รับสารพิษมากมาย ทั้งนิโคติน ไนโตรซามีน เบนโซไพรีน คาร์บอนมอนอกไซด์ ซึ่งเป็นอันตรายต่อสุขภาพ และอาจก่อให้เกิดโรคมะเร็งปอด และมะเร็งชนิดอื่นๆ ได้ในระยะยาว

ส่วนแอลกอฮอล์ เมื่อเข้าสู่ร่างกายจะเปลี่ยนเป็นอะซิทัลดีไฮด์ ซึ่งอาจก่อให้เกิดการกลายพันธุ์ของ DNA และนำไปสู่โรคมะเร็งได้ในผู้ที่ดื่มเป็นประจำ นอกจากนี้ แอลกอฮอล์ยังทำลายตับ ซึ่งเป็นอวัยวะสำคัญในการกรองสารพิษออกจากร่างกาย
3. ไม่ติดเชื้อเรื้อรัง
การติดเชื้อเรื้อรัง ไม่ว่าจะเกิดจากแบคทีเรียหรือไวรัส ล้วนเป็นปัจจัยเสี่ยงต่อการเกิดโรคมะเร็ง การอักเสบเรื้อรังจากการติดเชื้อเหล่านี้ สามารถกระตุ้นให้เซลล์ปกติกลายพันธุ์เป็นเซลล์มะเร็งได้
เช่น การติดเชื้อแบคทีเรีย เฮลิโคแบคเตอร์ ไพโลไร (HP) อาจทำให้เกิดมะเร็งกระเพาะอาหาร ไวรัสตับอักเสบบีเรื้อรังอาจทำให้เกิดมะเร็งตับ การติดเชื้อ HPV สายพันธุ์เสี่ยงสูงอาจทำให้เกิดมะเร็งปากมดลูก และไวรัส เอปสเตน-บาร์ มีความเกี่ยวข้องกับการเกิดมะเร็งโพรงจมูก
นอกจากนี้ ผู้ติดเชื้อ HIV ก็มีความเสี่ยงเป็นมะเร็งสูงขึ้น เนื่องจากภูมิคุ้มกันที่ลดลง การตรวจสุขภาพเป็นประจำ และเข้ารับการรักษาเมื่อพบความผิดปกติ จึงเป็นสิ่งสำคัญในการป้องกันโรคมะเร็ง
4. รักษาภาวะก่อนมะเร็ง
โรคมะเร็งไม่ได้เกิดขึ้นทันทีทันใด แต่จะมีระยะก่อนเป็นมะเร็ง ซึ่งหากตรวจพบและรักษาได้ทันท่วงที ก็จะสามารถลดความเสี่ยงของการเกิดโรคมะเร็งได้
เช่น ติ่งเนื้อในลำไส้ใหญ่ เป็นภาวะก่อนเป็นมะเร็งลำไส้ใหญ่ โรคกรดไหลย้อนเรื้อรัง เป็นภาวะก่อนเป็นมะเร็งหลอดอาหารและกระเพาะอาหาร เซลล์ปากมดลูกผิดปกติ เป็นภาวะก่อนเป็นมะเร็งปากมดลูก และตับอ่อนอักเสบเรื้อรัง เป็นภาวะก่อนเป็นมะเร็งตับอ่อน เป็นต้น การตรวจคัดกรองมะเร็งตามคำแนะนำของแพทย์ จึงเป็นสิ่งสำคัญในการตรวจพบภาวะก่อนเป็นมะเร็ง และเข้ารับการรักษาได้ทันท่วงที

5. กินอาหารที่ดีต่อสุขภาพ
การเกิดโรคมะเร็ง มีความสัมพันธ์อย่างใกล้ชิดกับพฤติกรรมการกินที่ไม่ดีต่อสุขภาพ เช่น การกินของหมักดอง อาหารปิ้งย่าง อาหารรมควัน ของทอด อาหารขึ้นรา เป็นต้น
นอกจากนี้ การชอบกินอาหารร้อนจัด อาหารแข็ง กินอาหารไม่เป็นเวลา หรือ กินจุ ก็เพิ่มความเสี่ยงโรคมะเร็งเช่นกัน การเลือกกินอาหารที่ดีต่อสุขภาพ เช่น ผัก ผลไม้ ธัญพืช และเนื้อสัตว์ที่ไม่ติดมัน จะช่วยลดความเสี่ยงของโรคมะเร็งได้

พฤติกรรมการกินที่อาจนำไปสู่โรคมะเร็ง
สมาพันธ์ควบคุมโรคมะเร็งนานาชาติ ระบุว่า โรคมะเร็งกว่า 80% เกี่ยวข้องกับพฤติกรรมการใช้ชีวิตที่ไม่ดีต่อสุขภาพ หากคุณไม่ใส่ใจดูแลสุขภาพ โรคมะเร็งก็จะถามหาได้ง่าย
กินอาหารไม่เป็นเวลา หลายคนอาจมีเหตุจำเป็นให้ต้องกินอาหารไม่เป็นเวลา ไม่กินอาหารเช้า หรือ กินดึก ซึ่งจะส่งผลเสียต่อกระเพาะอาหาร ทำให้เกิดโรคกระเพาะ หรืออาจนำไปสู่โรคมะเร็งได้ นอกจากนี้ การกินจุบจิบเป็นประจำ ทำให้ระบบย่อยอาหารทำงานหนัก และเพิ่มความเสี่ยงของโรคอ้วน ซึ่งเป็นปัจจัยเสี่ยงต่อการเกิดมะเร็ง
กินจุ การกินมากเกินไป เพิ่มความเสี่ยงของโรคอ้วน และเป็นอันตรายต่ออวัยวะย่อยอาหาร เช่น กระเพาะอาหาร และตับอ่อน หากเป็นเวลานาน อาจนำไปสู่โรคมะเร็งได้
ชอบดื่มแอลกอฮอล์ขณะกินอาหาร การดื่มแอลกอฮอล์เป็นประจำ ทำให้ DNA ซ่อมแซมตัวเองได้ไม่ปกติ เพิ่มโอกาสการเกิดโรคมะเร็งหลายชนิด เช่น มะเร็งตับ มะเร็งกระเพาะอาหาร มะเร็งตับอ่อน มะเร็งเต้านม มะเร็งต่อมลูกหมาก มะเร็งกล่องเสียง มะเร็งหลอดอาหาร
ไม่ชอบกินผัก คนที่ชอบกินอาหารไขมันสูง ของหมักดอง อาหารรมควัน แต่ไม่ค่อยกินผัก มีความเสี่ยงเป็นมะเร็งสูงขึ้น ผักใบเขียวมีวิตามินและไฟเบอร์สูง ช่วยกำจัดสารพิษ ฟื้นฟูเซลล์ที่ถูกทำลาย ลดไขมันในเลือด และป้องกันมะเร็ง
กินอาหารปิ้งย่าง ทอด อาหารเหล่านี้เมื่อผ่านความร้อนสูง จะเกิดสารก่อมะเร็ง เช่น เฮเทอโรไซคลิกเอมีน (heterocyclic amines) และ เบนโซไพรีน (benzopyrene) ซึ่งหากกินเป็นประจำจะเพิ่มความเสี่ยงของการเกิดโรคมะเร็ง นอกจากนี้ ร้านอาหารบางแห่งอาจใช้น้ำมันทอดซ้ำ ซึ่งยิ่งเพิ่มปริมาณสารก่อมะเร็ง และสารพิษอื่นๆ ที่เป็นอันตรายต่อร่างกาย
หากคุณมีพฤติกรรมเหล่านี้อยู่ ก็ควรปรับเปลี่ยนเสียใหม่ เพื่อสุขภาพที่ดี ห่างไกลโรคร้าย
ติดตาม The Thaiger บน Google News:





